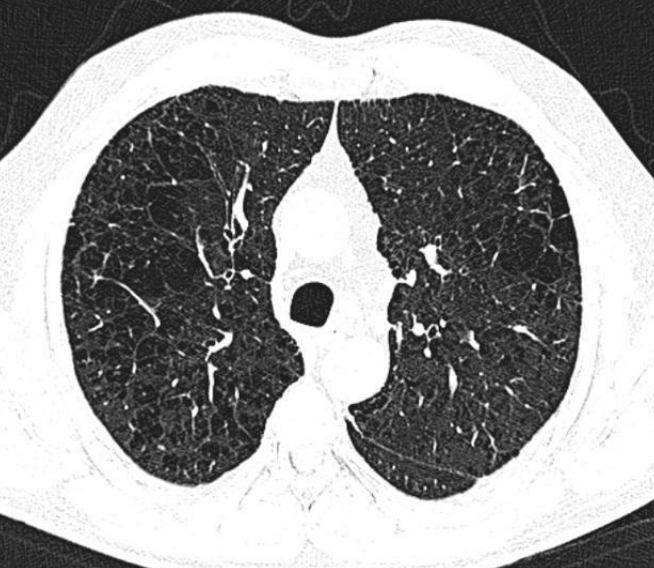

1
Q
RX ENFISEMA
A
Aplamaniendo de diafragma: se alcanzan a ver las 12 costillas
Corazón en gota
Hiperinsuflación
Hiperlucidez pulmonar
Disminución de marcas broncovasculares periféricas

2
Q
A

3
Q
TAC
A
Permite clasificar: centrolobulillar, panlobulillar, paraseptal
4
Q

A
Centrolobulillar

5
Q

A
Paraseptal

6
Q

A

7
Q
A
Centrolobulillar
8
Q

A
Panlobulillar
9
Q

A
Paraseptal
10
Q
Bronquitis crónica
RX y Tc
A
Patron intesticial grueso
Imágen en riel o tranvía: inflamación de pared bronquial
Manguitos peribronquiales: engrosamiento visto de frente
11
Q

A
Bronquitis crónica
12
Q

A
Manguitos peribronquiales: bronquitis crónica
13
Q

A
Manguitos peribronquiales
Tranvía


